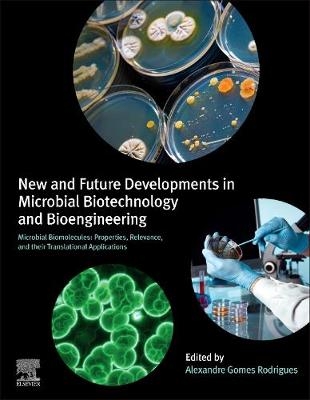
New and Future Developments in Microbial Biotechnology and Bioengineering -

New and Future Developments in Microbial Biotechnology and Bioengineering
Elsevier Science Ltd (Verlag)
978-0-444-64301-8 (ISBN)
In addition, the book describes strategic governmental programs designed to exploit biomass in a sustainable way, along with detailed information on research in several high-impact, worldwide laboratories. It gives concrete examples of ongoing research from molecules to methods, such as L-asparaginase, extremophiles, new diagnostics tools and the analytical methods that have raised the quality of the data obtained, thereby boosting the so-called bioeconomy.
Alexandre Gomes Rodrigues received his BSc in pharmacy in 2011 in Brazil. He expanded his interests into biotechnology and completed his MSc in an interdisciplinary project involving fungal proteins and metallic nanoparticles at Sao Paulo University. In 2014 he moved to Germany to pursue his PhD in pharmaceutical technology at Martin-Luther-University. His research interests cover the fields of pharmaceutical technology, biomaterials, and biotechnology. He has published scientific peer-reviewed articles and book chapters and has participated in international congresses and conferences in both biotechnology and pharmaceutics.
1. A Brief History of Microbiology
2. Biopharmaceutics Molecules
3. Biopharmaceutical Development, Production, And Quality
4. Antibodies and Microbial Biomolecules as Biotechnological Tools for Bacterial Infections Diagnosis
5. Microbial Production of Metabolites for Food and Processes
6. Fermented Beverages: Geographical Distribution and Bioactive Compounds with Health Benefits
7. Biofuels
8. Biosurfactants: The Use of Biomolecules in Cosmetics and Detergents
9. Global Players: Resources and Profits
10. Start-Ups and Prominent Business
11. Advanced Metabolic Engineering Strategies for Sustainable Processes
12. Biomolecules Produced by Extremophiles Microorganisms and Recent Discoveries
13. Policy Making in Biotechnology
14. Challenges and Opportunities
| Erscheinungsdatum | 08.06.2020 |
|---|---|
| Verlagsort | Oxford |
| Sprache | englisch |
| Maße | 216 x 276 mm |
| Gewicht | 1040 g |
| Themenwelt | Naturwissenschaften ► Chemie ► Technische Chemie |
| Technik ► Umwelttechnik / Biotechnologie | |
| ISBN-10 | 0-444-64301-X / 044464301X |
| ISBN-13 | 978-0-444-64301-8 / 9780444643018 |
| Zustand | Neuware |
| Informationen gemäß Produktsicherheitsverordnung (GPSR) | |
| Haben Sie eine Frage zum Produkt? |
aus dem Bereich


